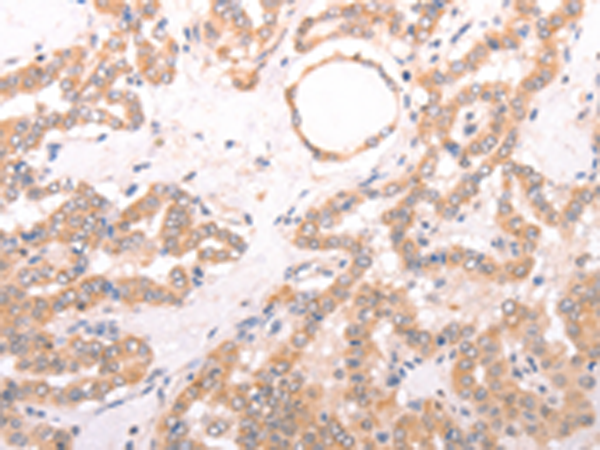
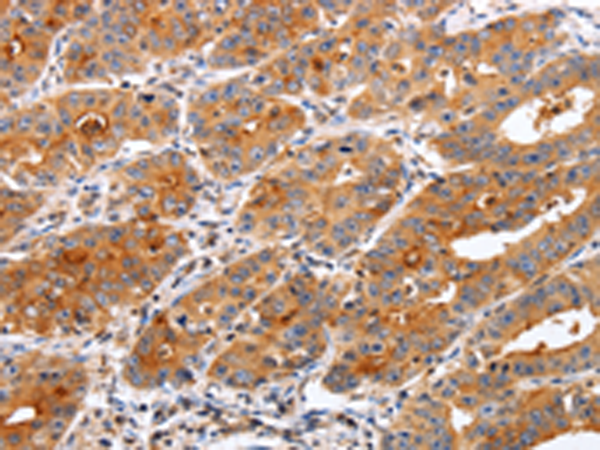

-
分类: 科研抗体货号: P07673别名: Hs.89862应用: WB,IHC反应种属: Human, Mouse
-
分类: 科研抗体货号: P07690别名: CTFP6; CTRP6; ZACRP6应用: IHC反应种属: Human
-
分类: 科研抗体货号: P07647别名: KHS; GCKR; KHS1; MAPKKKK5应用: IHC反应种属: Human, Mouse
-
分类: 科研抗体货号: P07689别名: SMAL; VRL2; CMT2C; SPSMA; TRP12; VROAC; HMSN2C; OTRPC4; SSQTL1应用: IHC反应种属: Human, Mouse, Rat
-
分类: 科研抗体货号: P07672别名: TRA16应用: IHC反应种属: Human, Mouse
-
分类: 科研抗体货号: P07646别名:应用: IHC反应种属: Human
-
分类: 科研抗体货号: P07687别名: CMH3; TMSA; CMD1Y; C15orf13; HTM-alpha应用: WB,IHC反应种属: Human, Mouse, Rat
-
分类: 科研抗体货号: P07670别名: TPRH; TRPH应用: IHC反应种属: Human, Mouse, Rat
-
分类: 科研抗体货号: P07645别名: DLK; MUK; ZPK; ZPKP1; MEKK12应用: IHC反应种属: Human, Mouse, Rat
-
分类: 科研抗体货号: P07665别名: CSC-21K应用: IHC反应种属: Human, Mouse, Rat

鄂公网安备42018502007531号
鄂公网安备42018502007531号

